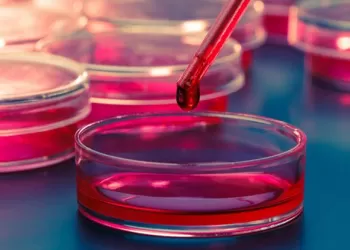
Sertleşme Sorununda Kök Hücre Tedavisi

- Anasayfa
- Hakkımda
- Kanserler
-
Hastalıklar
- Prostatit
- Benign Prostat Hiperplazisi
- Erkek Cinsel Fonksiyon Bozuklukları
- Kadın Cinsel Fonksiyon Bozuklukları
- İnterstisyel Sistit
- Erkek İnfertilitesi
- Ürolojik Taş Hastalıkları
- Ürolojik Enfeksiyonlar
- Kistik Hastalıklar
- İdrar Kaçırma/İdrar Yapamama
- Doğuştan Gelen Hastalıklar
- İdrar Yolu Darlığı
- Pelvik Taban Hastalıkları
- Tedaviler
- Hasta Yorumları
- Sağlık Köşesi
- Randevu Al
- Anasayfa
- Hakkımda
- Kanserler
-
Hastalıklar
- Prostatit
- Benign Prostat Hiperplazisi
- Erkek Cinsel Fonksiyon Bozuklukları
- Kadın Cinsel Fonksiyon Bozuklukları
- İnterstisyel Sistit
- Erkek İnfertilitesi
- Ürolojik Taş Hastalıkları
- Ürolojik Enfeksiyonlar
- Kistik Hastalıklar
- İdrar Kaçırma/İdrar Yapamama
- Doğuştan Gelen Hastalıklar
- İdrar Yolu Darlığı
- Pelvik Taban Hastalıkları
- Tedaviler
- Hasta Yorumları
- Sağlık Köşesi
- Randevu Al